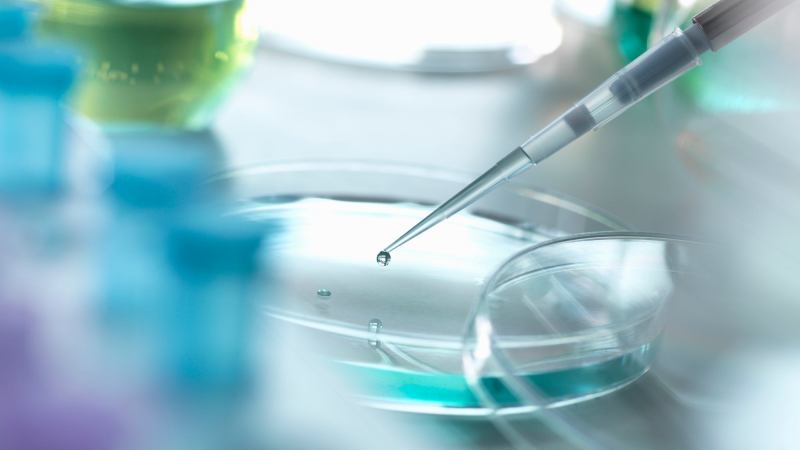

This Former Banking Executive Wanted to Help a Friend Suffering From Lupus. Now He Leads a BioTech Company on the Verge of a Breakthrough COVID Treatment.
Inside the “why” of Brian Foster’s move from finance to biotech.
In this ongoing series, we are sharing advice, tips and insights from real entrepreneurs who are out there doing business battle on a daily basis. (Answers have been edited and condensed for clarity.)
Who are you and what’s your business?
I had a 32-year career at JPMorgan and was a Vice Chairman of the Private Bank. After I left, I invested in BioIncept based on my interest to help develop therapeutic treatments with such great potential to treat the growing numbers that suffer from autoimmune disease, including a very close friend with Lupus. I was asked to take on the CEO role with a mandate to successfully advance BioIncept’s pipeline to patients and commercial success. They are obviously closely linked outcomes. My banking clients and now BioIncept investors respond well to getting things done in a first-class way.
Bioincept is focused on developing drug therapies and diagnostic capabilities that will be transformative to their treatment areas. They may be considered disruptive but I prefer to think of them as “enabling” —enabling recovery from serious disease or improving In Vitro Fertilization cycle success rates and potentially broader women’s health issues.
Was there a particular moment that launched this company?
BioIncept was founded around the discovery of the earliest biomarker of pregnancy – and the understanding that maternal immune acceptance is initiated by the embryo rather than the mother. Today, we leverage synthetic versions of the molecular drivers of the immune system protective effects that an embryo uniquely enjoys in the maternal-fetal interplay, into clinical and preclinical development programs that could benefit a number of patient populations, including those with autoimmune and cell damage related diseases.
Related: How This 18-Year-Old High School Student Built a 6-Figure Social Media Consulting Business
When COVID arrived, we saw that much of the damage it causes to tissues and organs was due to the body’s powerful immune response. We realized that our approach offers both the potential to reduce COVID-induced disease symptoms and uniquely, to promote the repair of the tissue damage to cardiac, neurological and pulmonary systems experienced by the majority of survivors.
We made the decision to pursue a clinical study to treat COVID “long haulers”, a term that refers to the large and growing population of survivors who have persisting symptoms.We expect most patients treated with our therapy will have a faster and more robust recovery.This is a unique therapy.We are incredibly excited to advance this clinical study as fast as possible.
From an entrepreneurial perspective, the decision to double up on the fight against COVID was one of several possible choices of how to allocate our resources, which is always somewhat a difficult straddle. Luckily, the work we are doing in COVID also directly supports our broader platform and will also benefit patients in the other disease areas we are targeting.
What advice would you give entrepreneurs looking for funding?
Look everywhere. Most importantly, work very hard at initial company formation to find others who share your commercial vision or have a similar passion to make a difference and get them involved if possible.Investors identify with themes and most often businesses or technology they understand. Funding is more than a full-time job for a CEO. So, whilst the introductions you may get from supporters may not ultimately affect an investor’s decision to invest or not – always expect they will make a full diligence – it is so valuable to even just get a foot in the door for an opportunity to voice your story.
How do you recommend entrepreneurs approach the pitch process?
Make your initial pitches to the least likely potential investor you can find, so that you can hone your messaging. They could come from general investor forums, family office groups, etc.– it is great practice and can get you feedback. Try to understand upfront what is of interest to the prospective investor so you can adapt your pitch to their interest.
Related: This Entrepreneur Is Building a Platform to Inspire the Next Elon Musk
As you advance to more curated prospective investors, do all your homework, not just some. This includes their fund website, prior investments, industry experience, and have a hypothesis on why your investment opportunity is especially relevant to them.You may think this is obvious, but you would be shocked what investors are sometimes confronted with… so you need to stand out! If they show interest, try to understand why so the next interaction can be more informed. Whilst it is harder during the days of video conferences to read ones personality, it is easier to get a “slot” and engage. Overall, the goal should be understanding what you did well and how to improve on what did not go well.
Identify potential investors with alignment to your business or end product.If your product has the potential to expand to new markets, think about who could benefit and would they have a reason to invest. If your product or service is complimentary to another that could enhance sales of both or be cross-sold.
What has been your biggest challenge during the pandemic and how did you pivot to overcome it?
It became clear to us in February as we were advancing studies at two universities in Baltimore, Maryland that COVID would shut down most drug development activity that wasn’t relevant to COVID. It was a coincidence that our drug had the potential to treat and repair the damage inflicted by the virus, but it proved essential that we began our pivot that same day and quickly refocused our resources while we still could before the shut-down. As an entrepreneur, when you get a momentary gut instinct that you should pivot, you usually should, because the fastest first-step has much less friction and more optionality.
Where do you see this company in a year? In five years?
A year from now, we’ll understand the disease progression of COVID-19 better, and in five years, we expect to be in position to benefit a lot of patients to halt and most importantly recover from challenging autoimmune diseases, as well as to have enabled a transformation in IVF success. And we will be able to speak openly about some other exciting topics we are currently working on under the radar.
If successful, we should have completed our clinical studies and advanced several of our therapies closer to patient use. We should also have become a trusted partner to IVF centers on helping them deliver successes to their patients.
In a lot of ways, as with technology development in other areas, entering into a clinical study flashes the next number of years before your eyes, both because you have to choreograph where you think the results may take you, and also because you have to be ready to take a different trajectory than you planned.
What does the word “entrepreneur” mean to you?
Entrepreneur means you are all in. You have little time for other things and you have to sweat the details. You have to plan for success but most importantly be creative and resilient when things fail. As a small biotech, resilience, bouncing back and keeping things moving forward is the most important skill set for survival.
Related: He Built the Netflix for Music Creation
Is there a particular quote or saying that you use as personal motivation? Explain how it inspires you.
“When you come to a fork in the road, take it,” by Yogi Berra. Developing novel technologies does not always proceed in a straight line. It’s intellectually challenging; staying sharp, facing facts and adapting to deal with challenges are critical for survival and success. Working hard to find the right path is highly motivating.
In this ongoing series, we are sharing advice, tips and insights from real entrepreneurs who are out there doing business battle on a daily basis. (Answers have been edited and condensed for clarity.)
Who are you and what’s your business?
I had a 32-year career at JPMorgan and was a Vice Chairman of the Private Bank. After I left, I invested in BioIncept based on my interest to help develop therapeutic treatments with such great potential to treat the growing numbers that suffer from autoimmune disease, including a very close friend with Lupus. I was asked to take on the CEO role with a mandate to successfully advance BioIncept’s pipeline to patients and commercial success. They are obviously closely linked outcomes. My banking clients and now BioIncept investors respond well to getting things done in a first-class way.






